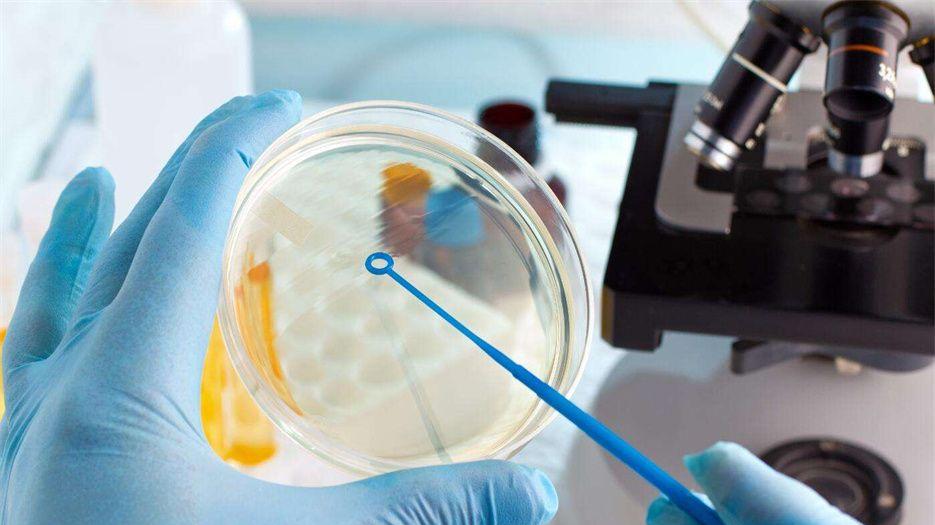

截止2022年初,根据卫健委公布的名单来看,目前重庆市可开展试管婴儿试管婴儿技术的生殖中心共有7家,其中排名较为靠前的有2家生殖中心,分别是:陆军军医大学西南医院,重庆市妇幼保健院。具体详细介绍如下,方便大家参考做出选择。

重庆市试管婴儿试管生殖中心排名如下,以下排名不分先后,只以省级行政区划和准入时间排序。
排名第一的医院是:陆军军医大学西南医院
西南医院是一家综合性教学医院,前身是国民政府“中央医院”,1929年始建于南京,1941年迁至重庆,1951年定名为“西南医院”,现为第三军医大学第一附属医院和第一临床医学院。
西南医院生殖中心的试管婴儿的成功率已经提高了不少,从原来的20%-25%左右已经提高到60%甚至更高的水平。并且根据每个人的身体情况不同试管成功率可能会更高。试管费用大概在3-8万元左右。
排名第二的医院是:重庆市妇幼保健院
重庆市妇幼保健院创建于1944年,是一所集临床医疗、妇幼保健、科研教学为一体的三级甲等妇幼保健院。医院设有妇科、产科、生殖内分沁科、乳腺专科、生殖与遗传、不孕症专科、性病专科、计划生育科、儿科、新生儿科、口腔科等三十多个科室。
重庆市妇幼保健院2001年首批通过卫生部关于“试管婴儿”技术的审批,到目前为止,生殖与遗传研究所已诞生试管婴儿2000多名,是全国最大的生殖中心之一。当前来说该医院的试管成功率大概在70%左右,但试管婴儿的成功率会受多方面因素,不可一概而论,还需要从自身出发综合来看。
值得注意的是:目前卵源稀缺是国内普遍现象,也就是说,不仅仅是重庆市存在卵源稀缺,整个国内现在卵源都是处于稀缺现状。这主要是由于国内对于卵源的管控十分严格,公立医院允许试管助孕成功后且还有富余的卵子才能捐献,而进行试管助孕的家庭,往往在取卵的过程中并不是十分顺利,在经过培育胚胎的过程中也会出现卵子损耗,成功培育后在移植阶段也可能需要多次移植,因此卵子的损耗率是较高的,能够剩余的可能性也并不多,再加上即使有富余的家庭大多数都不会选择捐献,而是会选择冷冻保存,为下一次生育做准备。
由此可见,卵源现阶段处于匮乏状态。此种情况下就导致了不少需求卵源的人群往往会选择正规的医疗机构来获取卵源,实现生育。很多正规的医疗机构在卵源上有着极大的优势,卵源稳定,充足,匹配率高且快,这就是为什么大多数人选择医疗机构的原因之一。但我们在医疗机构的选择上也一定要多方面考察后才能决定,以免身心受创,人财两空。

重庆市有试管婴儿的医院生殖中心成功率及费用介绍
1、陆军军医大学西南医院
试管婴儿成功率:45%-70%;普通试管婴儿费用:3-8万元,详情建议咨询生殖中心医生。
2、重庆市妇幼保健院
试管婴儿成功率:40%-75%;普通试管婴儿费用:3-10万元,详情建议咨询生殖中心医生
小结:重庆市有试管婴儿的生殖中心有7家,但试管婴儿试管周期高的只有2家,但这2家医院的生殖中心的卵源是并不充足,如果有试管婴儿试管需求建议多预约几家医院,同时也可以寻求其他医疗机构,但是一定要选择正规的医疗机构。也可以咨询下生殖专家,希望你好孕。










